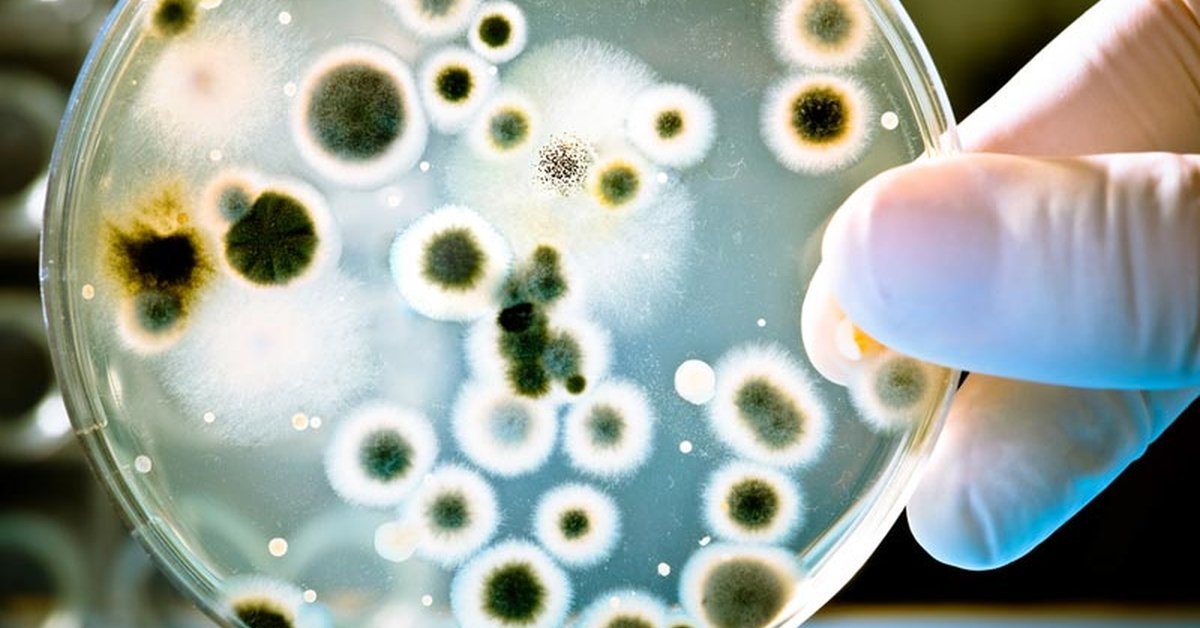

ಟ್ವೀಟ್ಗಳು
- ಟ್ವೀಟ್ಗಳು
- ಟ್ವೀಟ್ಗಳು & ಪ್ರತಿಕ್ರಿಯೆಗಳು
- ಮಾಧ್ಯಮ
@calcalist ತಡೆಹಿಡಿಯಲಾಗಿದೆ
ನೀವು ಖಚಿತವಾಗಿಯೂ ಈ ಟ್ವೀಟ್ಗಳನ್ನು ನೋಡಲು ಬಯಸುವಿರಾ? ಟ್ವೀಟ್ಗಳನ್ನು ನೋಡುವುದು @calcalist ಅವರನ್ನು ತಡೆತೆರವುಗೊಳಿಸುವುದಿಲ್ಲ.
-
אובמה עוזב את הבית הלבן, זמן לסכם את ההישגים הבולטים שלו - וגם את הכישלונות הגדוליםpic.twitter.com/R4DgSbJ0KP

-
המדינה מערערת על עונשו של נוחי דנקנר: דורשת 3-5 שנות מאסרpic.twitter.com/3yykVHdOBt

-
האם בקרוב לרובוטים יהיו זכויות כמו לבני אדם? באירופה כבר נערכים לקראת החיים לצידם, כולל הגדרת זכויות וחובות. למה צריך את זה בכלל?pic.twitter.com/IrtDvloP4V
-
בני שטיינמץ גרף 5 מיליארד דולר בזכות השוחד שנתן לנשיא גינאה לשעברhttp://www.calcalist.co.il/articles/0,7340,L-3706104,00.html …
-
מאחורי הבית הזה בתל אביב מסתתר סכסוך ענק על פרויקט של 2.5 מיליארד שקל http://ow.ly/fL2n3089aGg pic.twitter.com/MLmWt64vpa

-
רשות החברות הממשלתיות משנה את אופן חישוב הבונוסים, במטרה להגדיל את מספר הנשים בתפקידים בכיריםhttp://ow.ly/rSdv30898Y7
-
הענקית הסינית מאמינה בעדשות החכמות של החברה הישראליתhttp://ow.ly/29lU30895wv
-
מחזיקי האג"ח של אפריקה ישראל מאוכזבים: ההצעה הקודמת של בעל השליטה בחברה היתה נדיבה יותרhttp://ow.ly/5jld30895op
-
-
קק"ל כמשל: המפעל הציוני בשירות מקורביםhttp://www.calcalist.co.il/articles/0,7340,L-3706109,00.html …
-
ראש ממשלה לא יכול לנהל מדינה כשהוא עסוק בחקירות - אז פשוט ניתן לו פטור מהן. הנה הצעת החוק של ח"כ דוד אמסלם מהליכודpic.twitter.com/P4cvT4vzuI

-
בעקבות ההרשעה הפלילית: לשכת עורכי הדין מבקשת לשלול זמנית את הרישיון של נוחי דנקנרpic.twitter.com/ykS8i6au3z

-
רגע לפני טראמפ והטענות על קונספירציה סינית מאחורי "ההתחממות הגלובלית": אובמה אישר 500 מיליון דולר לקרן ליישום הסכם האקליםpic.twitter.com/ASBEkpTglS

-
כשבכיר פייסבוק נכנס לפגישה עם עיתונאים ישראלים הוא נשא 2 עוגות שוקולד ביתיות. נחשו איך הוא קרא להן...http://www.calcalist.co.il/articles/0,7340,L-3706089,00.html …
-
אובמה עוזב את הבית הלבן כשארה״ב בחוב של 20 טריליון דולר!! אבל מה זה אומר בעצם? טור שלי מהיום http://www.calcalist.co.il/world/articles/0,7340,L-3706013,00.html … (בתמונה: מוטרדים מהחוב)pic.twitter.com/LyHaSbyvnC

-
קנסות שלא ירתיעו עבריינים, בלי התייחסות לאכיפה - משרד התחבורה מנסה לטפל בסימפטומים ולא בבעיה עצמהhttp://ow.ly/G6fZ3087cYE
-
רשתות הקפה לא מחכות למשרד הבריאות: החלו בהחלפת מכונות שבהן יש חשש לחריגה בעופרתpic.twitter.com/zjOPjWst3A

-
דוח המבקר: קקל נהגה כמו הדרקון בהוביט - צברה הררי זהב ושכבה עליהםhttp://www.calcalist.co.il/local/articles/0,7340,L-3706039,00.html …
-
-
שופרסל מזהירה: חשש לחיידקי ליסטריה באפונה וגזר קפואים של החברה באריזת 800 גרם, מהסדרה שהתוקף שלה הוא יולי 2018pic.twitter.com/BpP2mHpIAo
ಲೋಡಿಂಗ್ ಸಮಯ ಸ್ವಲ್ಪ ತೆಗೆದುಕೊಳ್ಳುತ್ತಿರುವಂತೆನಿಸುತ್ತದೆ.
Twitter ಸಾಮರ್ಥ್ಯ ಮೀರಿರಬಹುದು ಅಥವಾ ಕ್ಷಣಿಕವಾದ ತೊಂದರೆಯನ್ನು ಅನುಭವಿಸುತ್ತಿರಬಹುದು. ಮತ್ತೆ ಪ್ರಯತ್ನಿಸಿ ಅಥವಾ ಹೆಚ್ಚಿನ ಮಾಹಿತಿಗೆ Twitter ಸ್ಥಿತಿಗೆ ಭೇಟಿ ನೀಡಿ.


 כלכליסט | Calcalist
כלכליסט | Calcalist
 Naomi Zoreff
Naomi Zoreff
 Calcalist Technology
Calcalist Technology

 Shahar Ilan
Shahar Ilan
 Omer Kabir•עומר כביר
Omer Kabir•עומר כביר
 Uri Pasovsky
Uri Pasovsky